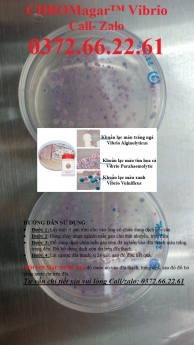

Chọn nơi ghim tin

Tìm kiếm gần đây
Từ khóa phổ biến
Đồ điện tử
Xe cộ
Bất động sản
Ship
Máy tính để bàn
Máy ảnh, Máy quay
Điện thoại di động
Xe đạp
Xe máy
Ô tô
Mua bán nhà đất
Đất
Dịch vụ - Giải trí
Thực phẩm, đồ uống
Thời trang
Mẹ và Bé
Đồ gia dụng
Sức khỏe - Sắc đẹp
Nội thất - Ngoại thất
Khuyến mại - Giảm giá
Thủ công - Mỹ nghệ - Quà tặng
Nhà trong ngõ
Căn hộ chung cư
Nhà riêng, nguyên căn
Nhạc cụ
Sách
Cửa hàng
Văn phòng
Máy tính bảng
Tivi, Loa, Amply, Máy nghe nhạc
Phụ kiện
Xe tải, xe khác
Phụ tùng xe
Xe đạp điện
Xe máy điện
Nội thất ô tô
Thời trang nam
Thời trang nữ
Đồ đôi, đồng phục
Thời trang bé
Giày dép
Thú cưng
Tìm việc làm
Đồ cho mẹ và bé
Thiết bị điện lạnh
Thiết bị nhà bếp
Thiết bị theo mùa
Thiết bị sức khỏe
Đồ gia dụng khác
Mỹ phẩm
Spa
Vật tư - y tế
Thể thao
Dịch vụ
Sở thích khác
Dụng cụ thể thao
Du lịch
Đồ dùng văn phòng, công nông nghiệp
Nội thất phòng khách
Nội thất phòng ngủ
Nội thất phòng bếp
Nội thất phòng tắm
Nội thất văn phòng
Vườn
Thiết kế, phong thủy
Nội thất khác
Hoa, quà tặng, handmade
Nghệ thuật, thủ công
Thực phẩm, Đồ uống
Thực phẩm
Đồ uống
Laptop
Thiết bị đeo thông minh
Sưu tầm đồ cổ
Thiết bị chơi game
Thời trang thể thao
Phụ kiện thể thao
Dụng cụ làm đẹp
Thực phẩm chức năng
Gà
Chó
Mèo
Chim
Đồ ăn, phụ kiện, dịch vụ
Thú cưng khác
Đồ dùng văn phòng
Công nông nghiệp
Ngoại thất
Linh kiện

Mô tả
Mô tả




 0
0 0
0 0
0 0
0 0
0
 0
0 0
0























Chia sẻ
Bình luận